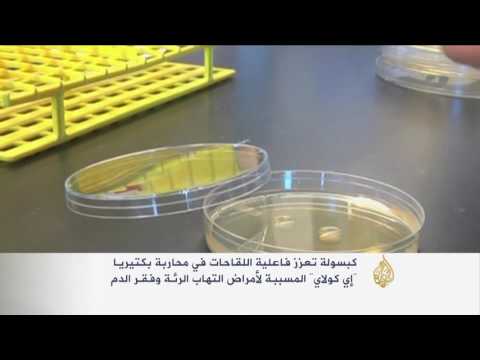
بالفيديو  كبسولة حيوية تحارب بكتيريا إي كولاي

-
الرئيسية
- أخبار الرياضة المغربية والعربية والعالمية
- أخبار الرياضة والرياضيين
- نجوم الملاعب
- فيديو أخبار الرياضة
- أخبار الرياضة
- ملاعب مغربية
- بطولات
- أخبار الاندية المغربية
- مقابلات
- رياضة عالمية
- رياضة عربية
- مباريات ونتائج
- سالب
- موجب
- كرة الطائرة
- كرة اليد
- كرة السلة
- رمي
- قفز
- الجري
- تنس
- سيارات
- غولف
- سباق الخيل
- مصارعة
- جمباز
- تحقيقات
- أخبار المنتخبات
- مدونات
- أخبار المحترفين
-
كرة قدم مغربية
كرة قدم عربية
كرة قدم عالمية
رياضات مختلفة
-
الرجاء البيضاوي
الوداد الرياضي
-
الجيش الملكي
-
الفتح الرباطي
-
اتحاد طنجة